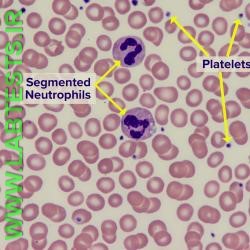
Thumbnail
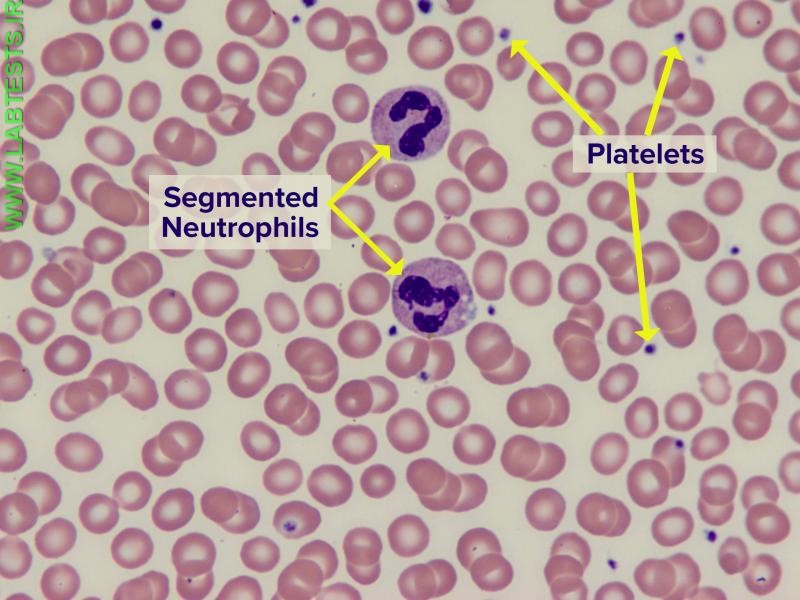
Blood smear showing RBCs, WBCs, platelets

To evaluate your red blood cells (RBCs), white blood cells (WBCs), and platelets, to distinguish between the different types of WBCs, and to determine their relative percentages in the blood; to help detect, diagnose, and/or monitor a range of deficiencies, diseases, and disorders involving blood cell production, function, and lifespan
Blood Smear
When complete blood count (CBC) and/or automated WBC differential results are abnormal or when you have signs and symptoms that a health practitioner suspects are due to a condition affecting your blood cells
A blood sample drawn from a vein in your arm or by pricking a finger, ear or, in the case of an infant, a heel
None
-
How is it used?
A blood smear is often used as a follow-up test to abnormal results on a complete blood count (CBC) to evaluate the different types of blood cells. It may be used to help diagnose and/or monitor numerous conditions that affect blood cell populations.
For the test, a drop of blood is spread thinly onto a glass slide that is then treated with a special stain. Traditionally, trained laboratorians have examined blood smears manually using a microscope. More recently, automated digital systems have become available to help analyze blood smears more efficiently.
At one time, a blood smear was prepared on nearly everyone who had a CBC. With the development of more sophisticated, automated blood cell counting instruments, it has now become routine to provide an automated differential. However, if the results from an automated cell count and/or differential indicate the presence of abnormal white blood cells (WBCs), red blood cells (RBCs), and/or platelets or if there is reason to suspect that abnormal cells are present, then a blood smear will be performed.
A blood smear is often used to categorize and/or identify conditions that affect one or more type of blood cells and to monitor individuals undergoing treatment for these conditions. There are many diseases, disorders, and deficiencies that can affect the number and type of blood cells produced, their function, and their lifespan. Examples include anemia, myeloproliferative neoplasms, bone marrow disorders, and leukemia.
Usually, only normal, mature or nearly mature cells are released into the bloodstream, but certain circumstances can induce the bone marrow to release immature and/or abnormal cells into the circulation. When a significant number or type of abnormal cells are present, it can suggest a disease or condition and prompt a health practitioner to do further testing. Depending on the findings from a CBC and blood smear, follow-up testing may include tests such as:
-
When is it ordered?
The blood smear is primarily ordered to evaluate blood cells when a CBC with differential, performed with an automated blood cell counter, indicates the presence of abnormal or immature cells. It may also be performed when a person has signs and symptoms that suggest a condition affecting blood cell production or lifespan.
Examples of signs and symptoms that may indicate one of these blood disorders include:
- Weakness, fatigue
- Pale complexion
- Unexplained jaundice
- Fever
- Excessive bleeding episodes, easy bruising, or frequent nose bleeds
- Enlargement of the spleen
- Bone pain
A blood smear may also be ordered on a regular basis when a person is being treated or monitored for a blood cell-related disease.
-
What does the test result mean?
Findings from a blood smear evaluation are not always diagnostic in themselves and more often indicate the presence of an underlying condition, its severity, and the need for further diagnostic testing. The results are taken into consideration with the results of the CBC and other laboratory tests as well as the tested person's clinical signs and symptoms.
The results of a blood smear typically include a description of the appearance of the red blood cells, white blood cells, and platelets as well as any abnormalities that may be seen on the slide.
Red Blood Cells (RBCs)
Normal, mature red blood cells are uniform in size (7-8 µm in diameter) and do not have a nucleus as most other cells do. They are round and flattened like a donut with a depression in the middle instead of a hole (biconcave). Due to the hemoglobin inside the RBCs, they appear pink to red in color with a pale center after staining the blood smear. When the appearance of RBCs (RBC morphology) is normal, it is often reported as normochromic and normocytic.While not every RBC will be perfect, any significant number of cells that are different in shape or size may indicate the presence of disease. Some examples of conditions that can affect red blood cells include:
- Anemia
- Hemoglobin variants including sickle cell anemia and thalassemia
- Leukemia
- Myeloproliferative or myelodysplastic neoplasms
- Bone marrow disorders
There may be one or more RBC irregularities seen on a blood smear. Two examples include:
- Anisocytosis — variable sizes of red blood cells may indicate anemia; RBCs smaller than normal are referred to as microcytes and RBCs larger than normal are called macrocytes.
- Poikilocytosis — various shapes of red cells; these may include echinocytes, acanthocytes, elliptocytes, keratocytes, rouleaux, sickle cells, target cells, teardrop cells, and shistocytes.
See the section below for Details on Red Blood Cell Irregularities.
White Blood Cells (WBCs)
As part of a blood smear evaluation, a manual WBC differential is performed. Typically, at least 100 WBCs are found, counted, and categorized according to type. The percentage of each type is calculated. In addition, the appearance (morphology) and stage of development of the WBCs are noted. White blood cells have a nucleus surrounded by cytoplasm. All WBCs are derived from bone marrow stem cells. In the bone marrow, they differentiate into two groups: granulocytic and lymphoid cells. They mature into five distinct types of WBCs.Those with granules in their cytoplasm are also called granulocytes and include:
- Neutrophils (10-18 µm) are cells that have cytoplasm with pink or purple granules. They compose the majority of WBCs in a healthy adult. They are involved in the defense against infections.
- Eosinophils (10-15 µm) are easily recognized in stained smears with their large, red-orange granules. Generally low in number (1-3%), they most often increase in number in individuals with allergies and parasitic infections.
- Basophils (10-15 µm) have large, black granules and are the least often seen type of WBC (1%).
The non-granulocytes include:
- Monocytes are usually the largest of the WBCs (12-20 µm) and are often referred to as scavenger cells (phagocytes). They can ingest particles such as cellular debris, bacteria, or other insoluble particles.
- Lymphocytes are smaller in size (10-12 µm) and have a small amount of cytoplasm and often a smooth, round nucleus. One type of lymphocyte, the B-cell, is responsible for the production of antibodies (immunoglobulins).
Numerous diseases and conditions can affect the absolute or relative number of WBCs and their appearance on a blood smear. Examples of some of the conditions include:
- Infections and/or inflammation — can increase certain types of WBCs
- Bone marrow disorders — depending on the condition, may increase or decrease absolute and relative numbers of WBCs
- Allergies — may affect the number of eosinophils
- Leukemia or myelodysplastic or myeloproliferative neoplasm — immature white blood cells such as blasts may be seen on the blood smear; blasts are normally found in the bone marrow where WBCs are produced and mature before being released into the blood. If blasts are seen on a blood smear, they may indicate a serious bone marrow disease.
See the section below for more Details on White Blood Cells.
Platelets
These are cell fragments that develop from large bone marrow cells called megakaryocytes. Upon release from the bone marrow, they appear as fragments in the peripheral blood. When there is blood vessel injury or other bleeding, the platelets become activated and begin to clump together to form aggregates, which is the beginning of a blood clot.There must be a sufficient number of platelets to control bleeding. If there are too few, of if they don't function properly, the ability to form a clot becomes impaired and can be a life-threatening situation. In some people, too many platelets may be produced, which may result in interferences with the flow of blood, increasing a person's risk of developing a blood clot. These same people may also experience bleeding because many of the extra platelets may be dysfunctional even though they appear normal.
A platelet count is usually part of a CBC. An abnormally low number or high number of platelets may be further evaluated by preparing a blood smear to directly visualize any anomalies in shape or size. For example, large platelets or giant platelets may be seen in myeloproliferative neoplasms or immune thrombocytopenia, a condition in which the immune system inappropriately produces antibodies directed against platelets. (For more information, see the articles on Platelet Disorders and Excessive Clotting Disorders.)
-
Is there anything else I should know?
Findings on a blood smear that are abnormal are typically referred to a pathologist, often one with extensive experience in the study of blood (hematology), for further review and interpretation. Depending on the results, follow-up testing involving an examination of a bone marrow aspirate and biopsy may be required for a diagnosis.
Blood smears may be used to help diagnose malaria, a disease caused by a blood parasite. The parasite may be seen when a blood smear is examined under a microscope. Malaria rarely occurs in the U.S. and is usually only seen in travelers returning from areas where the parasite is more common (endemic). Therefore, the blood smear is not often used for this purpose in the U.S.
Some examples of situations or conditions that may affect or invalidate results of a blood smear include:
- Recent blood transfusion
- Elevated levels of protein
Values can fluctuate at times of illness or stress; intense exercise or smoking can also affect cell counts.
-
Why hasn't the automated blood cell counter totally replaced the blood smear?
It has on a routine basis, but the automated blood cell counter usually evaluates the red blood cells (RBCs), white blood cells (WBCs), and platelets based on their shape, size, and electrical or photometric properties. There can be some variation in each cell type and numbers the body produces due to a variety of physiological and external stimuli. Use of an automated instrument can often identify the presence of abnormal cells but lacks the ability to definitively subclassify them. Cell fragments and platelet clumps, particularly if they are large in size, can be mistakenly counted as WBCs, thus falsely elevating a white cell count. A laboratorian can see these abnormalities on a blood smear and has been trained to identify and classify them appropriately.
Traditionally, blood smear review/interpretation has been done manually using a microscope, which is time-consuming and could be inconsistent among laboratorians. Automated digital morphology systems are now available to help analyze blood smears more efficiently.
-
If a drop of blood on a slide contains millions of RBCs, thousands of WBCs, and hundreds of thousands of platelets, how can the laboratorian see individual cells?
A specific technique is used to spread the drop of blood out across a glass slide into a "thumbprint" shape. Along the edges of this thumbprint the cells are only a single layer thick. This allows the cells in this area to be individually counted and evaluated under the microscope.
-
Size
- Anisocytosis: this is a variation in size of RBCs; it may be an indication of anemia
- Macrocytosis: large RBCs that may be due to a vitamin B12 or folate deficiency. They are seen in megaloblastic anemia (e.g., pernicious anemia), chronic alcoholism, and myelodysplastic syndrome.
- Microcytosis: this is the presence of small RBCs that may be due to an iron deficiency anemia or to an inherited disorder such as thalassemia.
-
Shape
- Poikilocytosis is a variation in the shape of an RBC and may include several different abnormalities at the same time.
- Acanthrocytes (spur, thorn or spiculated cells): irregular shaped cells with 5-10 spicules; may be present in the blood of people who have had their spleen removed (splenectomy) and with, for example, chronic alcoholism (cirrhosis), hemolytic anemia, or thalassemia. They are also present in an inherited disorder called abetalipoproteineimia.
- Echinocytes (burr, crenated or berry cells): may have 10-30 blunt projections and often seen in people with renal failure; may be an artifact – something caused during sample preparation.
- Elliptocytes (ovalocyte): elliptical-shaped RBC seen in hereditary elliptocytosis and various anemias, myelofibrosis.
- Fragmented cells (Schistocytes, Keratocyte, Helmet cell): fragmented RBC of various shapes that may be seen in people with disseminated intravascular coagulation (DIC) or a vascular artificial device (prosthesis) such as a heart valve.
- Rouleaux: RBCs that appear as a stack of coins and seen in people with multiple myeloma or Waldenstrom macroglobulinemia.
- Sickle cells: crescent-shaped RBCs that are characteristic of sickle cell anemia.
- Target cells (leptocytes or codocytes): RBCs that resemble a bull's-eye; commonly seen in people with abnormal inherited forms of hemoglobin (hemoglobinopathies), thalassemia, and various anemias.
- Teardrop cells (dacrocytes): RBCs that resemble a teardrop; often seen in people with myelofibrosis and thalassemia.
- Spherocytosis: sphere-shaped RBCs that are often present in hereditary spherocytosis or due to an immune hemolytic anemia.
-
Color
- Hypochromasia: this may be seen in a variety of disorders including thalassemia and iron deficiency. The RBC is pale in color due to insufficient hemoglobin and contains a large, hollow middle (central pallor) of the cell.
- Hyperchromasia: the RBC is darker in color than normal; this may be due to dehydration or presence of spherocytes.
- Polychromasia: blue-staining RBCs, indicating that they are immature due to early release from the bone marrow.
-
Abnormal structures within the red blood cell
- Nucleated RBCs (NRBC, normoblasts): a very immature form of RBCs seen when there is a severe demand for RBCs to be released by the bone marrow or marrow involvement by fibrosis or tumor; may be seen in severe anemia, myelofibrosis, thalassemia, miliary tuberculosis, cancers that involve the bone marrow, and in chronic low oxygen levels (hypoxemia). Nucleated RBCs can be normal in infants for a short time after birth.
- Reticulocytes: these are immature RBCs that are usually a blue-staining (polychromatic) color. A few of these young red blood cells are normal in the circulation. Elevated numbers may be seen with acute blood loss, hypoxia, RBC destruction, sickle cell disease, glucose-6-phosphate dehydrogenase (G6PD) deficiency, and autoimmune hemolytic anemia.
- Siderocyte, sideroblast, ring sideroblast: When RBCs are stained with Prussian blue dye, iron granules may be seen. Sideroblasts are immature siderocytes and may actually form a ring pattern indicative of sideroblastic anemia.
- Basophilic stippling is dark blue dots inside the RBC; due to abnormal aggregation of ribosomes and polyribosomes and may be present in heavy metal poisoning (such as lead), nutritional deficiencies, or myelofibrosis.
- Heinz bodies: large inclusion bodies (granules) in the RBCs when stained with crystal violet; may be due to an enzyme (G6PD) deficiency, unstable hemoglobin variant, thalassemia, and autoimmune hemolytic anemia.
- Howell-Jolly bodies (small, round remnants of nuclear DNA inside cell): present in sickle cell anemia, hemolytic or megaloblastic anemias, and may be seen after a splenectomy.
- Cabot's Rings: threadlike inclusions that form a ring within the RBC; may be seen in a variety of anemias.
- Malarial parasites: in people with malaria, these parasites live inside RBCs and may be visible on a blood smear. This is not a routine finding; these parasites are usually found in those who live in or have traveled to areas where the disease is endemic.
-
Neutrophils
NEUTROPHILS (also called segmented neutrophils, segs, polymorphonuclear cells, polys, or PMNs) are about 12 microns in diameter and their function is to engulf and destroy invading organisms. They make up about 50-70% of the total WBC count in the blood and may have two to five nuclear lobes connected by a thin strand of nuclear material. This type of WBC may be seen in greater numbers during infections, malignancies, or extreme stress situations. The cytoplasm of neutrophils is pale and often contains small pink to purple granules. These granules (specific granules and azurophilic granules) contain certain enzymes and proteins that neutralize or destroy microorganisms. Bands are immature neutrophils with a U-shaped nucleus. A small percentage of bands is normal in the blood.
Anomalies of neutrophils may include:
- Toxic Granulation: large dark blue granules in the cytoplasm, associated with severe infection, tissue necrosis, chemical poisoning, and other toxic states.
- Vacuolization: vacuoles appear as holes in the cytoplasm and are frequently found in association with toxic granulation.
- Döhle bodies: irregular grayish or bluish inclusions in the peripheral cytoplasm of neutrophils; they are denatured aggregates of free ribosomes or rough endoplasmic reticulum that are often seen in association with toxic granules and vacuoles. They may be present in association with burns, trauma, acute or systemic infections, and may be present with exposure to cytotoxic agents (i.e., chemotherapy). They may also be seen after cytokine stimulation (e.g., G-CSF) or during a normal pregnancy.
- Auer Bodies (Auer Rods): unique, pink or red rod-shaped inclusions that are seen in very immature granulocytes ("blasts") in people with acute non-lymphocytic leukemias (i.e., acute myeloid leukemia; AML).
- Bands - increased numbers: immature neutrophils are normal in the circulation in small numbers, but if there is a percentage increase of them, there is said to be a "left shift." This may happen when an acute infection stimulates increased neutrophil production, causing the bone marrow to prematurely release some WBCs before they have matured to the neutrophil stage. Other immature forms that may sometimes be seen on a blood smear include myelocyte and metamyelocyte or even promyelocyte and myeloblast.
- Hypersegmentation: neutrophils with six or more nuclear segments; this is mainly associated with vitamin B12 and folate deficiency and myelodysplasia.
- Pelger-Huët: hereditary anomaly where neutrophils appear with fewer than two lobes; the nucleus is often in the shape of a peanut or dumbbell, or may consist of two lobes connected with an obvious filament. They may also appear in certain disease states such as myelodysplasia and is referred to a "pseudo- Pelger-Huët".
- Alder-Reilly granules: large, dark leukocyte granules that stain purple; they are indicative of mucopolysaccharidosis (an inherited enzyme deficiency disorder, Hurler's and Hunter's syndromes).
- Chédiak-Higashi granules: an inherited anomaly characterized by the presence of big red, blue, or greenish granules of variable size that are peroxidase positive and indicate a lethal metabolic disorder, they may be found in granulocytes, lymphocytes, and monocytes. People with this syndrome may exhibit neurological problems as well as a compromised immune system and photophobia. Death often ensues.
-
Lymphocytes
Lymphocytes are relatively small (7-10 µm) and round in shape. The nucleus is generally large in relation to the amount of cytoplasm. The cytoplasm is pale blue and generally does not contain any granules. The nucleus of most lymphocytes is smooth in appearance and is dark blue. There are two major types of lymphocytes, B cell and T cell, but they cannot be distinguished when viewed under the microscope using standard staining techniques. B cells can be differentiated from T cells using specific fluorescent-labeled antibody stains in conjunction with a special instrument called a flow cytometer. B cells create specific antibodies while T cells can activate B cells as well as recognize and destroy invading organisms. Lymphocytes make up about 20% to 40% of the total WBC count.
- Reactive Lymphocyte (atypical lymphocyte, activated, Downey cells): these cells are large lymphocytes that contain a greater amount of cytoplasm and can vary in size and shape. Often a characteristic bluish tinge of cytoplasm is seen where the cell abuts with surrounding RBCs. Increased numbers of atypical lymphocytes are found in viral illnesses such as infectious mononucleosis.
- Hairy Cells: these lymphocytes have tiny projections that make them appear hairy under the microscope; they are found in hairy cell leukemia.
-
Eosinophils
-
Monocytes
Monocytes are the largest in size of the WBCs and comprise less than 6% in normal blood. They are characterized by their abundant blue-grey cytoplasm that is irregular in shape and have a folded nucleus. The main function of monocytes is to ingest microorganisms and respond to infection and inflammation by releasing certain proteins (monokines) that can inactivate bacteria. When stimulated by cytokines, monocytes can move out of the bloodstream and become tissue macrophages.
-
Basophils
Basophils have a multi-lobed nucleus and have many dark blue granules (which contain histamines) in their cytoplasm. Only about 1% of WBCs are basophils. A sight elevation in number may be seen during an allergic response, ulcerative colitis, chronic sinusitis, chickenpox, or immunizations. A significant increase is not uncommon in certain myeloid leukemias.